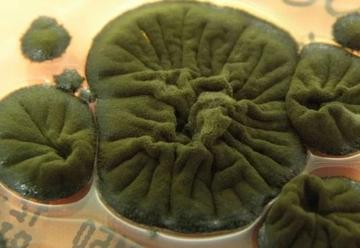
437743

'Görünmez' Avrupa ülkesi turizmde patlama yaşadı
Avrupa gezilerinde çoğu kişi Paris, Prag ya da İspanyol sahillerini düşünse de istatistikler başka bir ülkeyi zirveye taşıdı. Türklerin vizesiz olarak seyahat edebildiği Moldova'da 2025'in ilk altı ayında 2019'a kıyasla yüzde 62 daha fazla turist ağırlandı.
Dünyanın radarına pek girmediği için 'Avrupa'nın görünmez ülkesi' olarak adlandırılan Moldova, 2025'te turizmde büyük bir sürpriz yaptı. Birleşmiş Milletler Dünya Turizm Örgütü (UN Tourism) verilerine göre ülke, 2025'in ilk altı ayında 2019'a kıyasla yüzde 62 daha fazla yabancı turiste kapılarını açtı.
Bu artışla Moldova, Avrupa'da turizm büyüme hızında sadece Arnavutluk'un arkasında yer aldı. Gezgin Türkler de 90 güne kadar vizesiz seyahat edebildiği için Moldova'yı favori ülkeleri arasında tutuyor.
MOLDOVA'YI GERÇEKLİK CAZİP KILIYOR
Moldova'nın çoğu turist için en güçlü yani, bugün Avrupa'da nadir bulunan ham, gerçek ve hiç makyajlanmamış atmosferi. Sovyet döneminden kalma dev beton anıtlar, 90'lardan kalma minibüslerle ulaşım, SSCB'yi kitaplardan değil, hafızasından bilen insanlarla sohbet, köylerde restore edilen eski malikanelerin butik otellere dönüşmesi...
EN UCUZ ÜLKELERDEN BİRİ
Moldova, Avrupa'nın en ucuz seyahat noktalarından biri olarak da dikkat çekiyor:
- Ülkenin başkenti Kişinev'de ortalama bir öğle yemeği 8-9 dolara (yaklaşık 340-380 TL arası) mal oluyor.
- Kaliteli bir kadeh yerel şarap ise 2-4 dolar (yaklaşık 85-170 TL arası).
Dünyanın en büyük şarap mahzenine (Mileştii Mici) ev sahipliği yapan ülkedeki oldukça ucuz fiyatlı şarap turları da bağ gezmeyi seven turistlerin ilgisini bir hayli çekiyor.
MOLDOVA'DA GEZİLECEK YERLER
- Soroca Kalesi: Masalsı görünümlü bir Orta Çağ kalesi.
- Kişinev - Stefan cel Mare Parkı: Çeşmeleri ve gölgeli yürüyüş yollarıyla şehirde nefes alma noktası olarak tanımlanıyor.
- Transdinyester (Transnistria): TikTok'ta 'var olmayan ülke' diye meşhur olan, Sovyet nostaljisi dolu bölge.
TÜRKLERDEN VİZE İSTEMİYOR
Türkiye Cumhuriyeti pasaportuna sahip yolculardan, Moldova'ya kısa süreli (90 güne kadar) seyahatlerde vize istenmiyor. Bu da ülkeyi Türklerin Avrupa'daki favori noktalarından biri haline getiriyor.
sözcü
Yorum Ekle
Diğer Haberler
Çernobil'de ortaya çıkan mantar şoke etti: Radyasyon yiyerek büyüyor
Çernobil’in harabeye dönmüş, yıllardır kimsenin yaklaşmaya cesaret edemediği o ölümcül atmosferinde beklenmedik bir hayat formu ortaya çıktı. Felaketin gölgesinde doğan bu siyah mantarlar...
Kritik Dosya Yeniden Gündemde! Netanyahu Hakim Karşısında
İsrail Başbakanı Binyamin Netanyahu, af başvurusunun ardından yolsuzluk suçlamalarıyla ilgili davalarda ilk kez hakim karşısına çıktı.
Rusya'dan Çin'e vize uygulamasını kaldırma kararı
Rusya, Çin vatandaşlarına yönelik vize uygulamasını kaldırılma kararı aldı. Devlet Başkanı Vladimir Putin, Çinli ziyaretçilerden vize talep edilmemesini öngören kararnameyi imzaladı.
Azerbaycan’da muhalefet lideri gözaltına alındı
Azerbaycan Halk Cephesi Partisi Genel Başkanı Ali Kerimli’nin güvenlik güçlerince gözaltına alındığı bildirildi. Kerimli’nin danışmanı Fuad Gahramanlı, Kerimli’nin telefonlarına ulaşılama...
Portekiz veya İspanya değil: Emeklilik için en iyi ülke açıklandı, şaşırtıcı
International Living’in 2026 Emeklilik Endeksi, yıllardır listenin favorileri olan Portekiz ve İspanya’nın tahtını salladı. Beklenmedik bir ülke zirveye yerleşti. Her yıl yüz binlerce kiş...
Trump’tan Maduro’ya ‘derhal git’ ültimatomu
ABD Başkanı Donald Trump’ın Nicolás Maduro’ya “derhal istifa et” ültimatomu verdiği ve buna karşılık Caracas’ın küresel af ve ordu kontrolü talebi üzerine görüşmelerin tıkandığı öne sürüldü.
PKK’dan küstah açıklama! Abdullah Öcalan şartı
Terör örgütü PKK’nın sözde yöneticileri, AFP’ye yaptıkları açıklamada Abdullah Öcalan serbest bırakılmadan hiçbir adım atmayacaklarını bildirdi. Terör örgütü PKK’nın sözde yöneticilerinde...
Trump: 'Venezuela hava sahası tamamen kapandı'
ABD Başkanı Donald Trump Venezuela hava sahasının kapatılacağını açıkladı. Sosyal medya mesajında havayollarını, pilotları, uyuşturucu ve insan kaçakçılarını uyardı. Çıkış Trump ile Madur...
SOSYAL MEDYA
MAGAZİN
Burak Özçivit Rusya'da kral ilan edildi, 20 milyon aldı
Son olarak 'Kuruluş Osman' dizisinde yer alan oyuncu Burak Özçivit, önceki gün Rusya'nın Astrakhan şehrinde bir etkinliğe katıldı. Etkinlikte kral ilan edilen Özçivit'in 20 milyon TL aldı...
TEKNOLOJİ
EDİTÖR'ÜN SEÇTİKLERİ
Günde ne kadar C vitaminine ihtiyacımız var?
Kış hastalıklarının kapıda olduğu bugünlerde C vitamini bağışıklık sistemimizi güçlendiren antioksidan olarak öne çıkıyor. İşte bu vitamini doğal yoldan ve yeteri kadar alma yolları. Kış aylarında soğuk algınlığı ve grip gibi hastalıklar artarken hastalıklara karşı kalkan görevi gören C vitamini önem kazanıyor.

Yorumlar
Bu haberde yorum bulunmamaktadir.